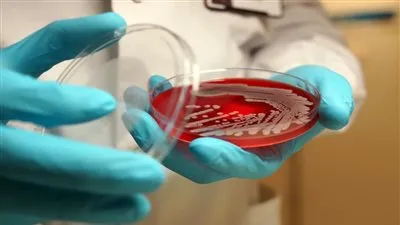
أعراضها وطرق الوقاية منها.. كل ما تريد معرفته عن بكتيريا مارسا

عاجل
أذكار مساء الجمعة.. كلمات من نور تحفظ القلب وتغمر النفس بالسكينة والطمأنينة
"وزيرة التضامن" تُثمّن جهود النيابة العامة وزياراتها التفتيشية لمؤسسات ودور رعاية الأطفال على مستوى الجمهورية
محافظة الجيزة تمنع إقامة سوق الجمعة العشوائي بشارع الدكتور لاشين بحي الهرم
محافظ القليوبية يفتتح 3 معارض "أهلًا رمضان" بطوخ وشبرا الخيمة
مناقشة قانوني الخدمة العسكرية وسجل المستوردين الأبرز بجدول أعمال النواب الأسبوع المُقبل